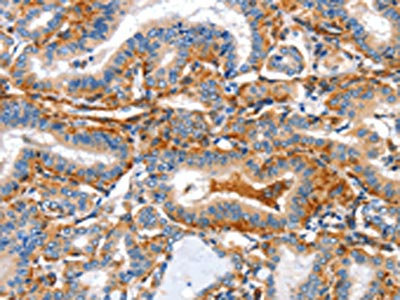

AIFM3 Antibody
-
中文名稱:AIFM3兔多克隆抗體
-
貨號:CSB-PA137629
-
規格:¥1100
-
圖片:
-
The image on the left is immunohistochemistry of paraffin-embedded Human cervical cancer tissue using CSB-PA137629(AIFM3 Antibody) at dilution 1/50, on the right is treated with fusion protein. (Original magnification: ×200)
-
The image on the left is immunohistochemistry of paraffin-embedded Human thyroid cancer tissue using CSB-PA137629(AIFM3 Antibody) at dilution 1/50, on the right is treated with fusion protein. (Original magnification: ×200)
-
Gel: 10%SDS-PAGE, Lysate: 40 μg, Lane: Hela cells, Primary antibody: CSB-PA137629(AIFM3 Antibody) at dilution 1/290, Secondary antibody: Goat anti rabbit IgG at 1/8000 dilution, Exposure time: 5 seconds
-
-
其他:
產品詳情
-
Uniprot No.:
-
基因名:AIFM3
-
別名:AIFL antibody; Aifm3 antibody; AIFM3_HUMAN antibody; Apoptosis inducing factor 3 antibody; Apoptosis inducing factor like antibody; Apoptosis inducing factor like protein antibody; Apoptosis inducing factor; mitochondrion associated antibody; Apoptosis-inducing factor 3 antibody; Apoptosis-inducing factor-like protein antibody; FLJ30473 antibody; FLJ45137 antibody
-
宿主:Rabbit
-
反應種屬:Human,Mouse
-
免疫原:Fusion protein of Human AIFM3
-
免疫原種屬:Homo sapiens (Human)
-
標記方式:Non-conjugated
-
抗體亞型:IgG
-
純化方式:Antigen affinity purification
-
濃度:It differs from different batches. Please contact us to confirm it.
-
保存緩沖液:-20°C, pH7.4 PBS, 0.05% NaN3, 40% Glycerol
-
產品提供形式:Liquid
-
應用范圍:ELISA,WB,IHC
-
推薦稀釋比:
Application Recommended Dilution ELISA 1:1000-1:5000 WB 1:200-1:1000 IHC 1:50-1:200 -
Protocols:
-
儲存條件:Upon receipt, store at -20°C or -80°C. Avoid repeated freeze.
-
貨期:Basically, we can dispatch the products out in 1-3 working days after receiving your orders. Delivery time maybe differs from different purchasing way or location, please kindly consult your local distributors for specific delivery time.
-
用途:For Research Use Only. Not for use in diagnostic or therapeutic procedures.
相關產品
靶點詳情
-
功能:Induces apoptosis through a caspase dependent pathway. Reduces mitochondrial membrane potential.
-
基因功能參考文獻:
- Upregulated expression of AIFM3 is associated with cholangiocarcinoma. PMID: 27473083
- The expression of apoptosis-inducing factor was identified in pineal gland and thymus, but it did not change with age. PMID: 22550867
- AIFM3 is a direct target of miR-210 in human hepatoma cells. PMID: 22387901
- AIFL has 598 amino acids, with a characteristic Rieske domain and a pyridine nucleotide-disulfide oxidoreductase domain (Pyr_redox). AIFL shares 35% homology with AIF, mainly in the Pyr_redox domain. PMID: 15764604
- AIF maintains the transformed state of colon cancer cells through its NADH oxidase activity, by mechanisms that involve complex I function. PMID: 16001080
- H. pylori triggers apoptosis in AGS cells via interaction with death receptors in the plasma membrane, leading to the cleavage of procaspase-8, release of cytochrome c and AIF from mitochondria, and activation of subsequent downstream apoptotic events PMID: 19166416
顯示更多
收起更多
-
亞細胞定位:Mitochondrion. Note=Does not translocate to the nucleus upon induction of apoptosis.
-
蛋白家族:FAD-dependent oxidoreductase family
-
組織特異性:Ubiquitous. Expressed in bone marrow, cerebral cortex, liver, ovary, thymus, thyroid gland and tongue (at protein level).
-
數據庫鏈接:
Most popular with customers
-
-
Phospho-YAP1 (S127) Recombinant Monoclonal Antibody
Applications: ELISA, WB, IHC
Species Reactivity: Human
-
-
-
-
-
-